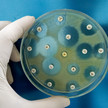
Recarbrio: Neues Antibiotikum bei Pneumonie Recarbrio: Neues Antibiotikum bei Pneumonie

Thema: neue AM
Artikel zum Thema
Erste Therapie bei IgA-Nephropathie Budesonid 2.0: Stada kooperiert mit Calliditas
Bislang gibt es in der EU keine zugelassene Behandlungsmöglichkeit für die Therapie der chronischen Autoimmunerkrankung IgA-Nephropathie (IgAN). Das könnte sich... Mehr»
Nosokomiale Infektionen Recarbrio: Neues Antibiotikum bei Pneumonie
Zur Behandlung von nosokomialen Infektionen werden dringend neue Wirkstoffe benötigt. Mit dem Kombinations-Antibiotikum Recarbrio (Imipenem, Cilastatin,... Mehr»
Chronische Herzinsuffizienz Verquvo: EU-Zulassung für Herzmedikament von Bayer
Bayer darf sein Herzmedikament Verquvo nun auch in der Europäischen Union verkaufen. Die Europäische Kommission habe Vericiguat zur Behandlung symptomatischer,... Mehr»
IgG4-Antikörper Adtralza: Neu bei Neurodermitis
Leo Pharma hat ein neues Medikament zur Behandlung der atopischen Dermatitis auf den Markt gebracht. Adtralza enthält den monoklonalen Antikörper Tralokinumab.... Mehr»
Casirivimab/Imdevimab/Regeneron Covid-19-Therapie: Erste Zulassung in Japan
Die japanischen Aufsichtsbehörden haben der Kombination aus Casirivimab und Imdevimab von Roche und Regeneron die Zulassung für die Behandlung von Patienten mit... Mehr»
Antikörper gegen ANGPTL3 Evkeeza: Neuer Cholesterolsenker
Regeneron hat für seinen Antikörper Evinacumab die EU-Zulassung erhalten. Evkeeza kann bei Jugendlichen ab 12 Jahren zur Senkung des Cholesterol-Wertes in... Mehr»
Colitis ulcerosa Tillots bringt neue Mesalazin-Zäpfchen
Tillots erweitert sein Asacol-Portfolio um Suppositorien. Pro Zäpfchen sind 1g Mesalazin enthalten. Die Zäpfchen werden zur Behandlung der Colitis ulcerosa... Mehr»
Phase-I/II-Studie Moderna entwickelt mRNA-Grippeimpfstoff
Das Biotech Unternehmen Moderna arbeitet aktuell an einem Grippeimpfstoff auf Basis der mRNA-Technologie. Das Unternehmen verkündet, dass die ersten... Mehr»
Speziell für Kinder Neo-Angin bringt Halsschmerzlolly
Klosterfrau erweitert die Marke Neo-Angin um einen Lolly gegen Halsschmerzen speziell für Kinder. Der nach Erdbeere schmeckende Lutscher soll Halsschmerzen... Mehr»
Erste orale Medikation MS: Aubagio ab 10 Jahren
Sanofi hat von der EU-Komission für Aubagio (Teriflunomid) die Zulassungserweiterung für die Altersgruppe ab zehn Jahren bekommen. Es ist die erste Zulassung... Mehr»
Medien zum Thema
- 1